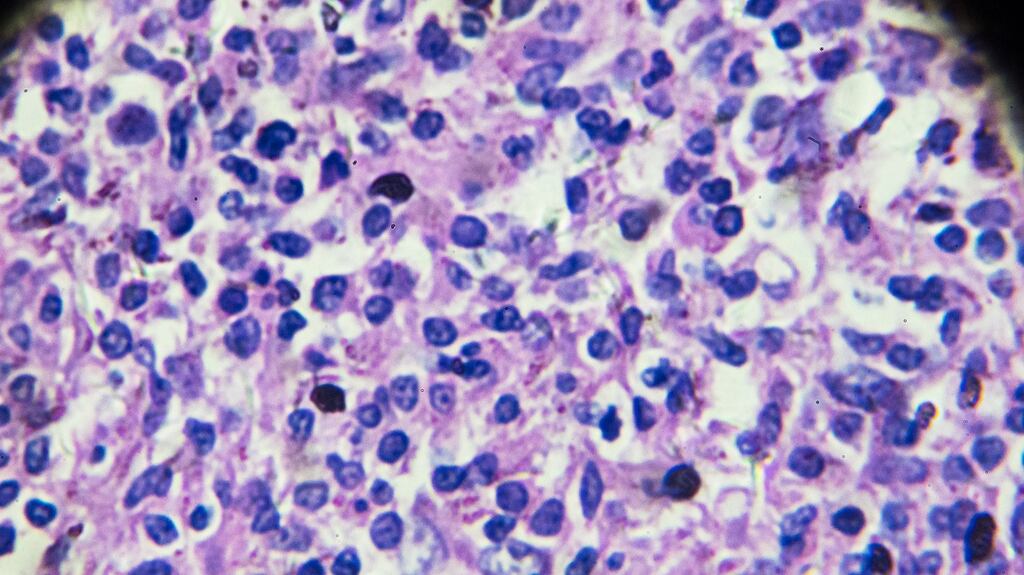
Drug delivery business Avectas has licensed a therapy from Galway-based ONK Therapeutics that targets what are called B-cell malignancies – blood cell cancers such as non-Hodgkin’s lymphoma (above)

Two cutting edge Irish pharmaceutical companies have announced a deal that they hope will deliver significantly improved treatment for people with certain cancers.
Drug-delivery business Avectas has licensed a therapy from Galway-based ONK Therapeutics that targets what are called B-cell malignancies – blood cell cancers such as non-Hodgkin's lymphoma and certain forms of leukaemia.
ONK has developed a process that genetically engineers natural killers cells – part of the body's immune system – to allow them better pursue cancer cells that have made themselves invisible to normal natural killer cells.
It has also added genetic material that makes the engineered cells more toxic for the target cancer cells, delivering a more effective therapy.
Avectas’s Solupure process allows the gene editing to be done rapidly and safely, without upsetting the cells in a way that also keeps the costs of the process down.
Upfront fee
Avectas, which last month announced a $20 million (€18.5 million) fundraising led by industry veteran Seamus Mulligan, will acquire 20 per cent of ONK as part of the deal. It will also retain worldwide development and commercialisation rights to the therapy.
Apart from the investment, ONK will receive an upfront fee as well as development and commercial milestones and royalties as the therapy progresses.
The two companies hope to have a product ready for clinical trials within two years – which ONK founder and managing director Prof Michael O’Dwyer noted was in large part down to the Avectas technology which is much faster than rival processes.
Unlike personalised medicine where a patient’s own cells are engineered and reintroduced to the body to fight disease, the Avectas/ONK link-up will engineer cells that can be used in many different patients suffering from these cancers. That “off the shelf” facility is seen by the two companies as giving them an advantage in what is a potential multibillion dollar market.
‘Breakthrough’
Avectas chief executive Michael Maguire said his company was "excited to collaborate with ONK and its expert team to develop this potentially breakthrough immuno-oncology therapy"
“While early clinical data with [the engineered] CAR NK cells appear promising, resistance is still an issue,” said Prof O’Dwyer. “Incorporation of our unique proprietary DR5 Trail variant into CAR-NK cells provides a powerful, complementary killing mechanism to overcome resistance, which may have applicability in a broad range of cancers.”